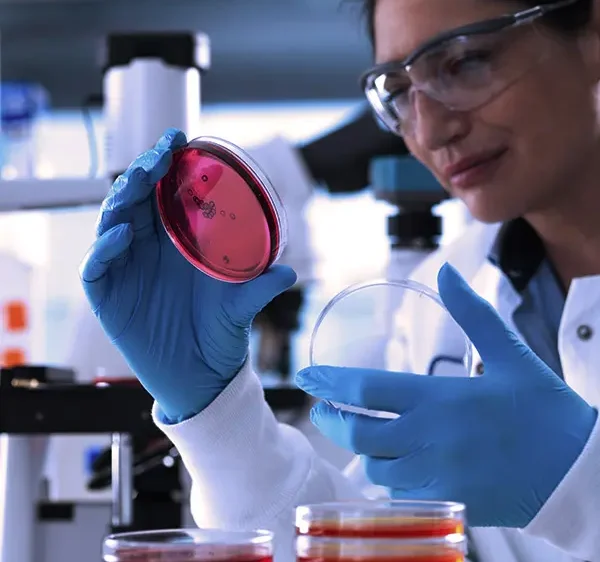

Modular Cleanroom Panels


Turnkey HVAC Cleanroom systems
Cleanroom Panels
Epoxy Flooring
Industry-first End-to-end Cleanroom Manufacturing in India
We assure you a custom, cost-effective, and superior clean environment that confidently surpasses traditional cleanroom standards. Our commitment to excellence means expedited timelines and optimised costs, delivering uncompromising quality, tailored precisely to your needs.
Testimonials
We take the opportunity to extend our sincere gratitude and appreciation, for the effort that Fabtech Technologies Cleanroom Pvt. Ltd. had extended in the timely completion of Cleanroom project at Plant 16, Ankleaswar Site. We extend our thanks to all the staff involved in the project. We wish them continued success and prosperity in all their future venture and assure that they will be considered in Glenmark future Projects
Eisai Pharmaceutical India Pvt. Ltd.
M/s. Fabtech Technologies Cleanroom Pvt. Ltd. has successfully completed our API Pilot plant expansion project at out Vizag plant. they have carried out this project to our satisfaction in terms of maintaining quality, time-lines and safety standard. The entire staff involved in this project has demonstrated very good attitude and cooperation. we wish Fabtech a great success in all their projects
Rajaram Consumer Care Pvt. Ltd
We award the certificate to Fabtech Technologies Cleanroom Pvt. Ltd. for their outstanding performance and efforts towards successful completion of cleanroom modular project for our Sangli Project. We wish them all the best and success to all the future ventures
We highly appreciate the efforts put in by Fabtech team for overcoming the hurdle of during execution. their ability to work through unforeseen challenges and collaborate approach is impressive and shows exceptional critical thinking skills a true dedication for the project. M/S Fabtech Team has met the quality and the other requirements as per our Standard. We have been having excellent support from the Entire team of Fabtech.
Our end-to-end cleanroom solutions ensure that our clients receive the highest quality service
Talk to us about your next project
Recent Articles
Our Clients










































Industries we Serve